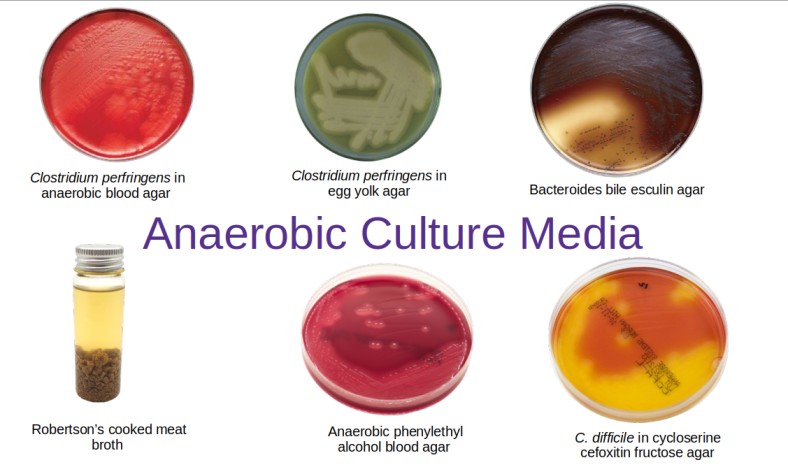
Various types of anaerobic culture media used in diagnostic bacteriology laboratory - Various types of anaerobic culture media are used in diagnostic bacteriology laboratory

Media used in anaerobic bacteriology can be freshly prepared or purchased from commercial suppliers. Media for anaerobic culture prepared in the laboratory should be used within two weeks of preparation as long storage degrades the quality of the media due to peroxide accumulation and dehydration. Anaerobic culture media contains reducing agents such as cysteine.
Pre-reduced, anaerobically sterilized media are produced by different commercial suppliers, which have extended shelf life up to six months. The primary plating media for inoculating anaerobic specimens includes a non-selective blood agar and one or all of the following mentioned selective media.
Nonselective media used in anaerobic bacteriology:
- Cooked meat broth (e.g. Robertson’s Cooked Meat Medium): Non-selective for the cultivation of anaerobic organisms; with the addition of glucose, can be used for gas-liquid chromatography.
- Anaerobic blood agar: It is a non-selective medium for the isolation of anaerobes and facultative anaerobes.
- Egg-yolk agar (EYA): Non-selective for determination of lecithinaseand lipase production by Clostridia and Fusobacteria.
- Peptone-yeast extract glucose broth (PYG): Non-selective for the cultivation of anaerobic bacteria for gas-liquid chromatography.
Selective and differential media used in anaerobic bacteriology:
- Bacteroides bile esculin agar (BBE): It is selective and differential for Bacteroides fragilisgroup and good for presumptive identification.
- Laked Kanamycin-vancomycin blood agar (LKV): It is selective for isolation ofPrevotella and Bacteroidesspp.
- Anaerobic phenylethyl alcohol agar (PEA): Selective for inhibition of gram-negative rods and swarming by some Clostridia.
- Cycloserine cefoxitin fructose agar (CCFA): Â Selective for Clostridium difficile.
- Thioglycollate broth: Nonselective for the cultivation of anaerobes; as well as facultative anaerobes and aerobes.
References
- Madigan Michael T, Bender, Kelly S, Buckley, Daniel H, Sattley, W. Matthew, & Stahl, David A. (2018). Brock Biology of Microorganisms (15th Edition). Pearson.
- Color Atlas and Textbook of Diagnostic Microbiology, Koneman, 5th edition
- Pelczar Jr., M., Chan, E., & Krieg, N. (2007). Microbiology (5th edition). Tata McGraw-Hill